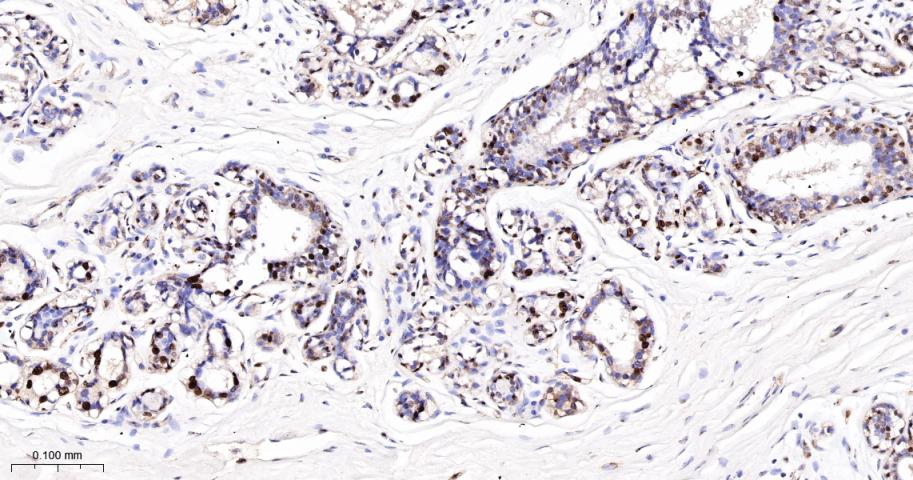
DNA修复酶Ku-80重组兔单抗

DNA修复酶Ku-80重组兔单抗
Rrmab?兔单抗

货号:bsm-52512R
产品详情
相关标记
相关产品
相关文献
常见问题
概述
产品编号
bsm-52512R
产品类型
重组兔单抗、mIHC精品抗体
英文名称
Ku80 Recombinant Rabbit mAb
中文名称
DNA修复酶Ku-80重组兔单抗
英文别名
KARP-1; KARP1; KU80; KUB2; Ku86; NFIV; CTC85; CTCBF; Kup80; XRCC5_HUMAN; XRCC5; 86 kDa subunit of Ku antigen; ATP-dependent DNA helicase 2 subunit 2; ATP-dependent DNA helicase II 80 kDa subunit; CTC box-binding factor 85 kDa subunit (CTC85 | CTCBF); DNA repair protein XRCC5; Lupus Ku autoantigen protein p86; Nuclear factor IV; Thyroid-lupus autoantigen (TLAA); X-ray repair complementing defective repair in Chinese hamster cells 5 (double-strand-break rejoining); 3.6.4.-; G22P2; XRCC5_MOUSE; Ku autoantigen protein p86 homolog;
抗体来源
Rabbit
免疫原
A synthesized peptide derived from human Ku80: 700-732/732
亚型
IgG
性状
Liquid
纯化方法
affinity purified by Protein A
克隆类型
Recombinant
克隆号
9C2
理论分子量
83 kDa
浓度
1mg/ml
储存液
0.01M TBS (pH7.4) with 1% BSA, 0.02% Proclin300 and 50% Glycerol.
SWISS
Gene ID
保存条件
Shipped at 4℃. Store at -20℃ for one year. Avoid repeated freeze/thaw cycles.
注意事项
This product as supplied is intended for research use only, not for use in human, therapeutic or diagnostic applications.
数据库链接
产品介绍
Ku80也是一种DNA修复蛋白,当细胞在受到辐射损伤而发生DNA双链断裂时,Ku80可迅速将其修复,从而提高细胞存活率。
Ku是一种多功能的蛋白,在许多重要的细胞生命过程中起着直接或间接的作用,如DNA双链断裂的修复,免疫球蛋白和T细胞受体V(D)J重排,免疫球蛋白构型转换,DNA复制,DNA转录的调节,同时在细胞周期的G2和M时相中起着特殊的作用。
Ku是一种多功能的蛋白,在许多重要的细胞生命过程中起着直接或间接的作用,如DNA双链断裂的修复,免疫球蛋白和T细胞受体V(D)J重排,免疫球蛋白构型转换,DNA复制,DNA转录的调节,同时在细胞周期的G2和M时相中起着特殊的作用。
背景资料
The protein encoded by this gene is the 80-kilodalton subunit of the Ku heterodimer protein which is also known as ATP-dependant DNA helicase II or DNA repair protein XRCC5. Ku is the DNA-binding component of the DNA-dependent protein kinase, and it functions together with the DNA ligase IV-XRCC4 complex in the repair of DNA double-strand break by non-homologous end joining and the completion of V(D)J recombination events. This gene functionally complements Chinese hamster xrs-6, a mutant defective in DNA double-strand break repair and in ability to undergo V(D)J recombination. A rare microsatellite polymorphism in this gene is associated with cancer in patients of varying radiosensitivity.

产品应用
| 应用 | 已检合格种属 | 预测种属 | 推荐稀释比例 |
|---|---|---|---|
| WB | Human | 1:500-2000 | |
| IHC-P | Human | 1:100-500 | |
| IHC-F | Human | 1:100-500 | |
| IF | Human | 1:100-500 | |
| ICC/IF | Human | 1:50-200 |
交叉反应
交叉反应: Human
相关产品
暂无相关产品
靶标
基因名
XRCC5
蛋白名
X-ray repair cross-complementing protein 5
亚基
Heterodimer of a 70 kDa and a 80 kDa subunit.
亚细胞定位
Nucleus. Chromosome.
相似性
Belongs to the ku80 family.
Contains 1 Ku domain.
Contains 1 Ku domain.
功能
Single stranded DNA-dependent ATP-dependent helicase. Has a role in chromosome translocation. The DNA helicase II complex binds preferentially to fork-like ends of double-stranded DNA in a cell cycle-dependent manner. It works in the 3'-5' direction. Binding to DNA may be mediated by XRCC6. Involved in DNA non-homologous end joining (NHEJ) required for double-strand break repair and V(D)J recombination. The XRCC5/6 dimer acts as regulatory subunit of the DNA-dependent protein kinase complex DNA-PK by increasing the affinity of the catalytic subunit PRKDC to DNA by 100-fold. The XRCC5/6 dimer is probably involved in stabilizing broken DNA ends and bringing them together. The assembly of the DNA-PK complex to DNA ends is required for the NHEJ ligation step. In association with NAA15, the XRCC5/6 dimer binds to the osteocalcin promoter and activates osteocalcin expression. The XRCC5/6 dimer probably also acts as a 5'-deoxyribose-5-phosphate lyase (5'-dRP lyase), by catalyzing the beta-elimination of the 5' deoxyribose-5-phosphate at an abasic site near double-strand breaks. XRCC5 probably acts as the catalytic subunit of 5'-dRP activity, and allows to 'clean' the termini of abasic sites, a class of nucleotide damage commonly associated with strand breaks, before such broken ends can be joined. The XRCC5/6 dimer together with APEX1 acts as a negative regulator of transcription.
标记抗体
暂无标记数据
同靶标产品
暂无同靶标产品
相关文献
提示: 发表研究结果有使用 bsm-52512R 时请让我们知道,以便我们可以引用参考文章。作为回馈,资料提供者将获得我们送上的小礼品。
具体参考文献:bsm-52512R 被引用于1文献中
暂无相关文献
常见问题
暂无常见问题